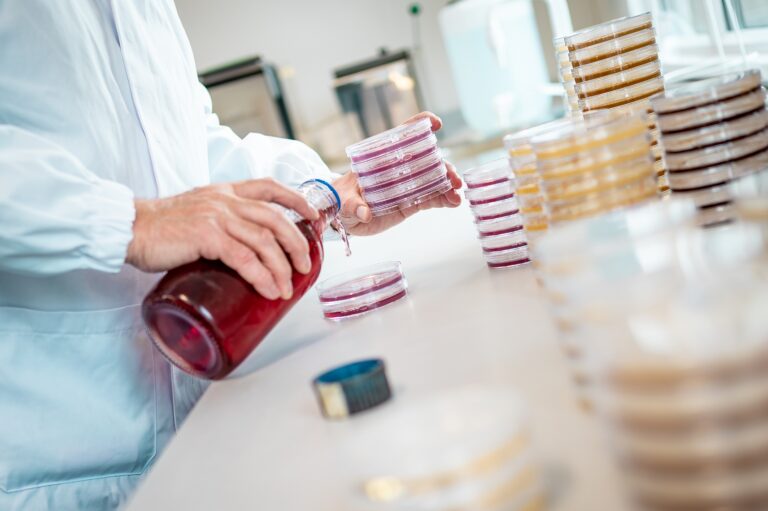
Moy Park invests £1 million in new Anwick facility

Moy Park has invested almost £1million in a new laboratory, which will enhance its food and agricultural testing capabilities.
The laboratory, recently constructed at the Moy Park’s site in Anwick, Lincolnshire, will be used to enhance the testing of environmental samples from the company’s agricultural estate and food products from its various processing sites.
The new facility will replace the existing lab and is significantly larger and has an innovative air handling system designed to protect air quality for personnel and the environment.
Ursula Lavery, Technical and R&D Director Europe at Moy Park, said the investment would build upon the company’s current in-house testing procedures and support its research and development projects,
“This latest investment further boosts our technical capabilities with state-of-the-art equipment that helps future-proof our operations. From supporting our business from farm to fork, the laboratory and our team of experienced scientists play a key role in delivering a quality service for our stakeholders. Through this investment we will continue to be at the forefront of technical excellence delivering safe, secure, and high-quality products to our customers and consumers.”